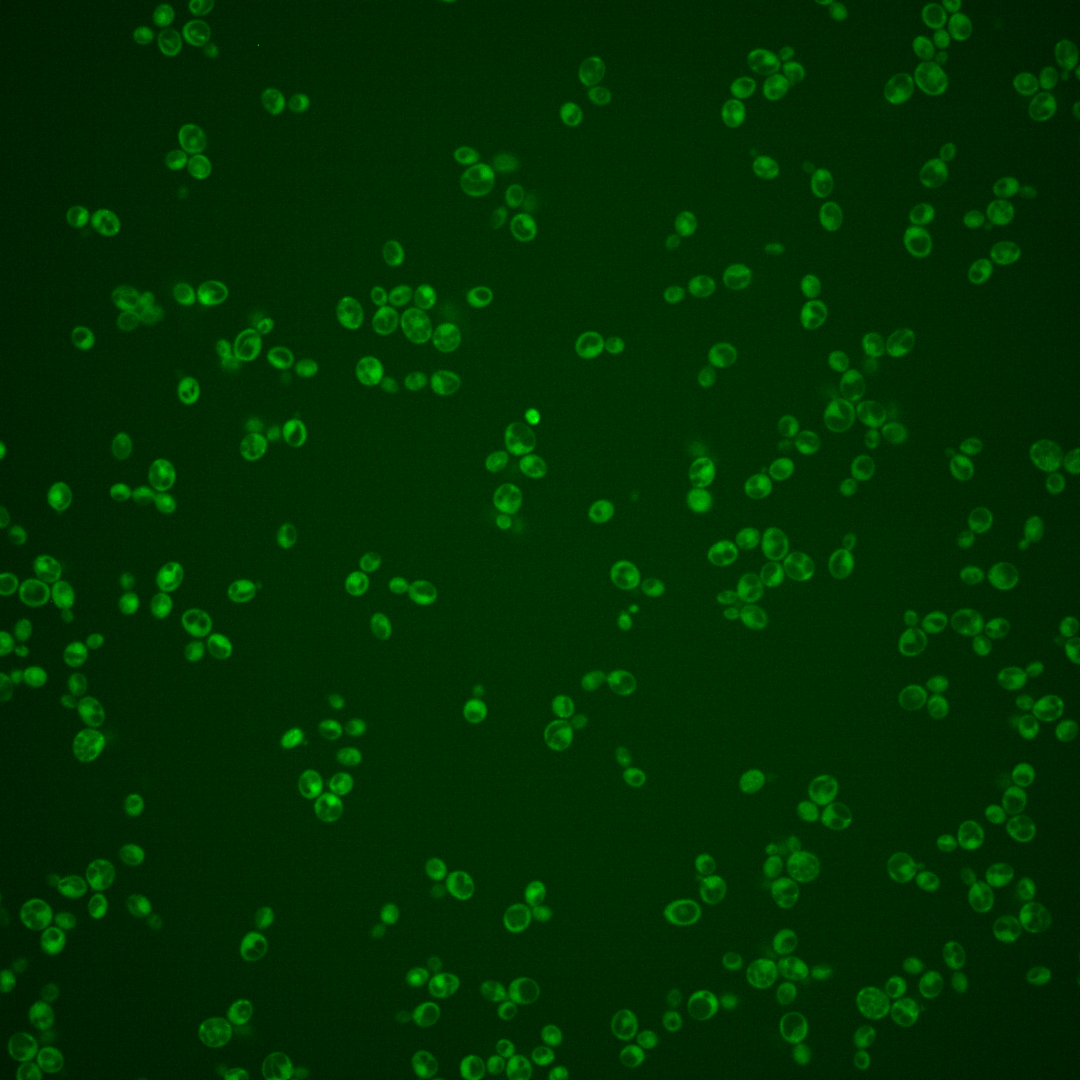
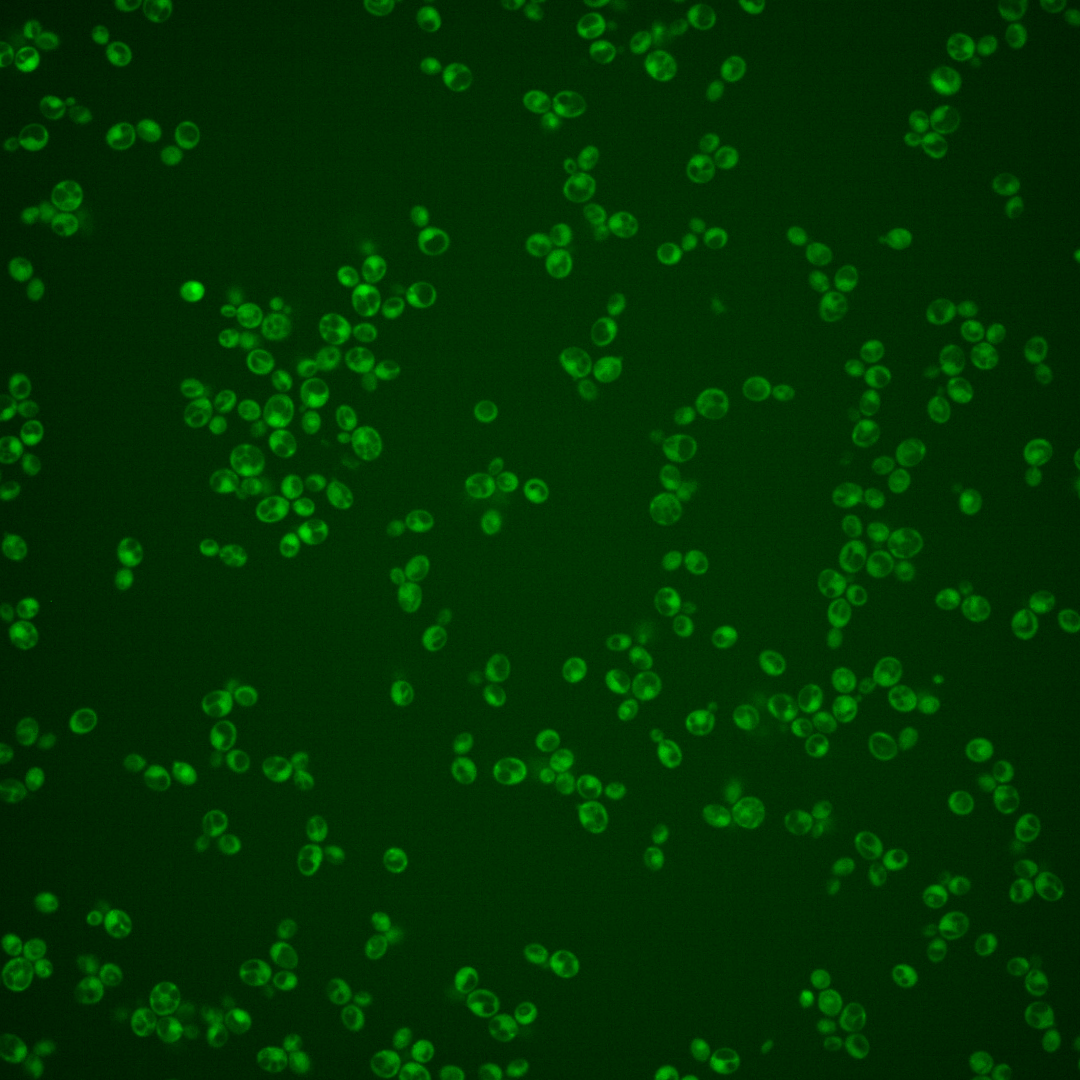
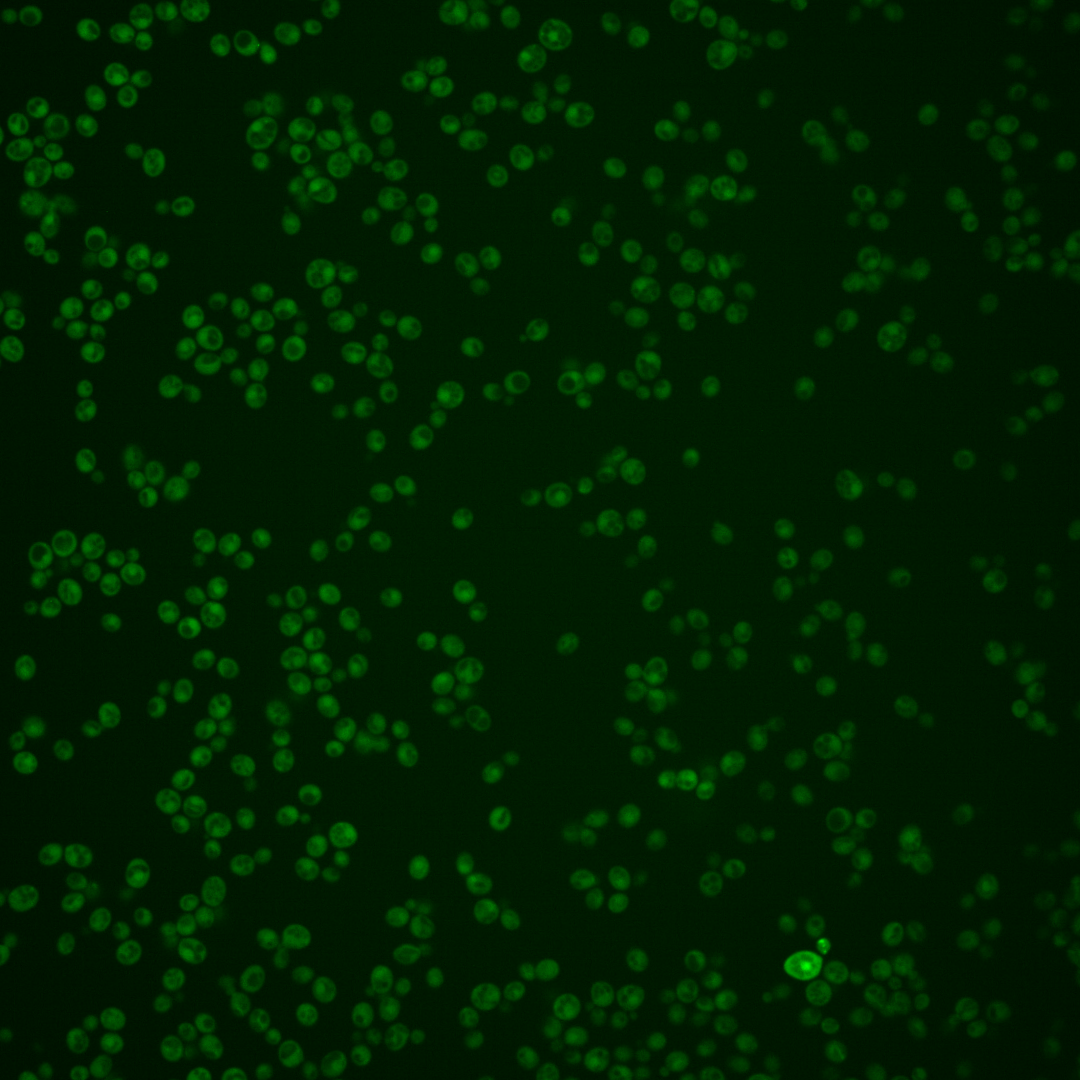
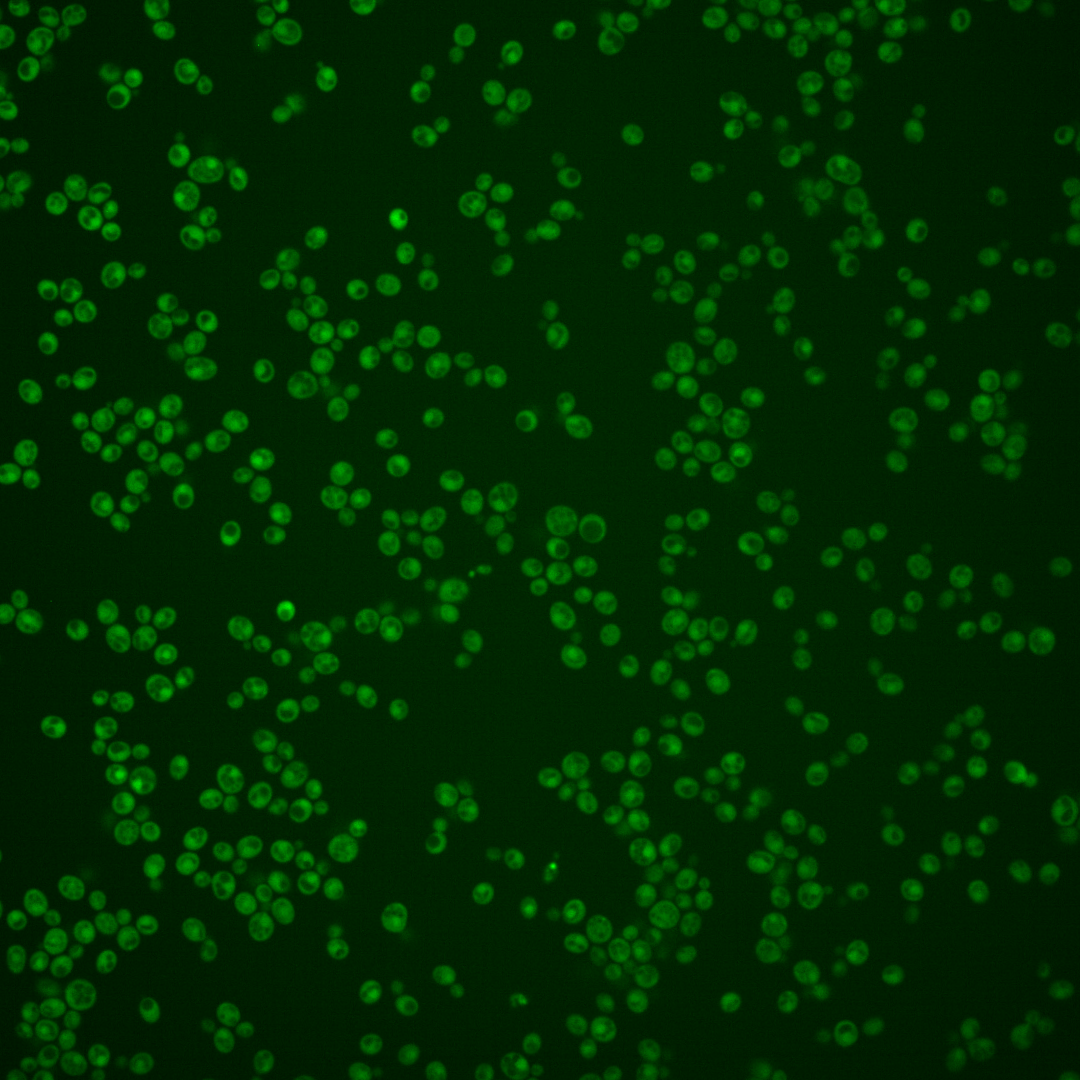
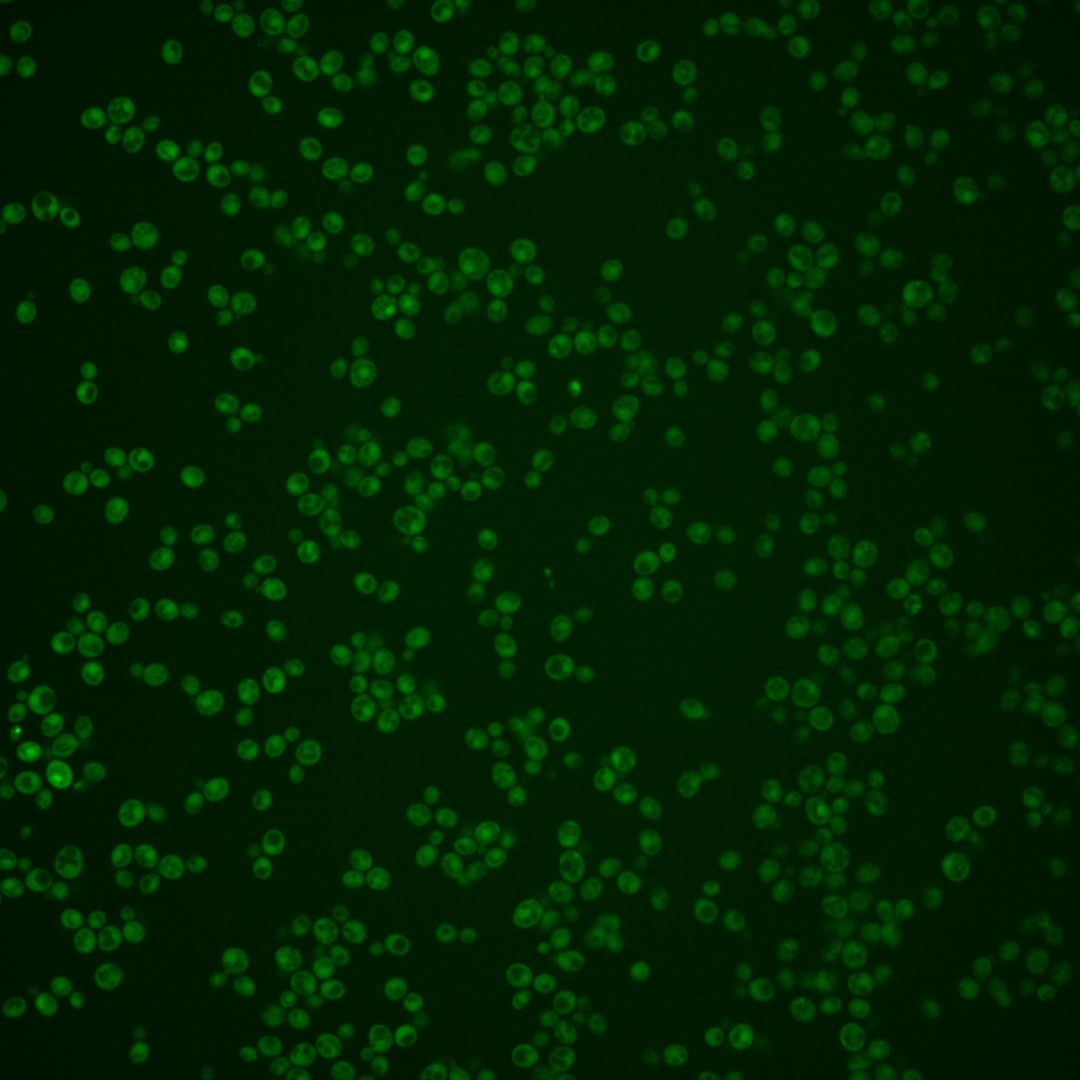

| Standard name | |
|---|---|
| Human Ortholog | |
| Description | 6-phosphogluconolactonase; protein abundance increases in response to DNA replication stress; SOL4 has a paralog, SOL3, that arose from the whole genome duplication |
Micrographs




















































































Sub-cellular Localization
Yeast GFP Assignment
Protein Abundance
Localization Change
External localization resources
| ensLOC | DeepLoc | |||||||||||||||||||||||
|---|---|---|---|---|---|---|---|---|---|---|---|---|---|---|---|---|---|---|---|---|---|---|---|---|
| Localization | WT1 | WT2 | WT3 | RAP60 | RAP140 | RAP220 | RAP300 | RAP380 | RAP460 | RAP540 | RAP620 | RAP700 | HU80 | HU120 | HU160 | rpd3Δ_1 | rpd3Δ_2 | rpd3Δ_3 | WT1 | WT2 | WT3 | AF100 | AF140 | AF180 |
| Cortical Patches | 0 | 0 | 0 | 0 | 0 | 0 | 0 | 0 | 0 | 0 | – | 0 | 0 | 0 | 0 | 0 | 0 | 0 | 1 | 1 | 0 | 1 | 0 | 0 |
| Bud | 0 | 2 | 0 | 0 | 0 | 0 | 1 | 1 | 1 | 1 | – | 0 | 0 | 0 | 0 | 0 | 0 | 0 | 2 | 9 | 0 | 1 | 0 | 2 |
| Bud Neck | 1 | 0 | 0 | 0 | 0 | 2 | 0 | 0 | 0 | 0 | – | 0 | 0 | 0 | 0 | 0 | 0 | 0 | 2 | 0 | 0 | 1 | 0 | 0 |
| Bud Site | 0 | 0 | 0 | 0 | 0 | 0 | 0 | 0 | 0 | 0 | – | 0 | 0 | 0 | 0 | 0 | 0 | 0 | – | – | – | – | – | – |
| Cell Periphery | 0 | 1 | 1 | 0 | 0 | 0 | 0 | 0 | 0 | 0 | – | 2 | 0 | 0 | 1 | 3 | 4 | 2 | 0 | 0 | 0 | 0 | 0 | 0 |
| Cytoplasm | 394 | 588 | 20 | 18 | 34 | 36 | 39 | 11 | 51 | 16 | – | 32 | 83 | 279 | 269 | 297 | 243 | 231 | 369 | 546 | 30 | 171 | 93 | 139 |
| Endoplasmic Reticulum | 0 | 1 | 0 | 0 | 1 | 0 | 0 | 0 | 1 | 0 | – | 0 | 0 | 0 | 0 | 8 | 13 | 9 | 0 | 0 | 0 | 1 | 0 | 0 |
| Endosome | 1 | 1 | 0 | 0 | 0 | 0 | 0 | 0 | 0 | 0 | – | 0 | 0 | 0 | 0 | 0 | 1 | 0 | 2 | 5 | 0 | 0 | 0 | 0 |
| Golgi | 1 | 0 | 0 | 0 | 0 | 0 | 0 | 0 | 0 | 0 | – | 0 | 0 | 0 | 0 | 1 | 1 | 0 | 4 | 4 | 0 | 0 | 0 | 0 |
| Mitochondria | 3 | 2 | 0 | 0 | 2 | 3 | 5 | 1 | 22 | 11 | – | 7 | 0 | 0 | 2 | 5 | 0 | 4 | 11 | 5 | 3 | 0 | 1 | 2 |
| Nucleus | 0 | 0 | 0 | 0 | 0 | 0 | 2 | 2 | 4 | 2 | – | 2 | 0 | 5 | 2 | 0 | 3 | 2 | 0 | 1 | 0 | 1 | 0 | 0 |
| Nuclear Periphery | 0 | 1 | 0 | 0 | 0 | 0 | 0 | 1 | 0 | 1 | – | 0 | 0 | 0 | 0 | 0 | 0 | 0 | 1 | 0 | 0 | 0 | 0 | 0 |
| Nucleolus | 0 | 0 | 0 | 0 | 1 | 0 | 0 | 0 | 0 | 0 | – | 0 | 0 | 0 | 0 | 0 | 0 | 0 | 0 | 0 | 0 | 0 | 0 | 0 |
| Peroxisomes | 0 | 0 | 0 | 0 | 0 | 0 | 0 | 0 | 0 | 0 | – | 0 | 0 | 0 | 0 | 0 | 0 | 0 | 0 | 0 | 0 | 0 | 0 | 0 |
| SpindlePole | 0 | 0 | 0 | 0 | 0 | 0 | 0 | 0 | 0 | 0 | – | 0 | 1 | 0 | 0 | 0 | 0 | 0 | 2 | 3 | 0 | 0 | 0 | 0 |
| Vac/Vac Membrane | 3 | 0 | 0 | 0 | 1 | 4 | 3 | 2 | 6 | 2 | – | 4 | 1 | 1 | 1 | 10 | 28 | 30 | 4 | 2 | 2 | 3 | 5 | 6 |
| Unique Cell Count | 402 | 592 | 20 | 18 | 37 | 43 | 47 | 17 | 73 | 25 | 42 | 85 | 283 | 271 | 304 | 255 | 243 | 409 | 586 | 40 | 188 | 104 | 159 | |
| Labelled Cell Count | 403 | 596 | 21 | 18 | 39 | 45 | 50 | 18 | 85 | 33 | 47 | 85 | 285 | 275 | 324 | 293 | 278 | 409 | 586 | 40 | 188 | 104 | 159 | |
Yeast GFP Assignment
Protein Abundance
| Screen | WT1 | WT2 | WT3 | RAP60 | RAP140 | RAP220 | RAP300 | RAP380 | RAP460 | RAP540 | RAP620 | RAP700 | HU80 | HU120 | HU160 | rpd3Δ_1 | rpd3Δ_2 | rpd3Δ_3 | AF100 | AF140 | AF180 |
|---|---|---|---|---|---|---|---|---|---|---|---|---|---|---|---|---|---|---|---|---|---|
| Mean Cell GFP Intensity (1e-4) | 4.4 | 5.1 | 4.5 | 4.4 | 5.3 | 5.9 | 6.2 | 6.3 | 5.7 | 5.7 | – | 6.9 | 6.1 | 7.3 | 8.1 | 9.8 | 12.1 | 11.6 | 9.7 | 5.9 | 10.4 |
| Std Deviation (1e-4) | 1.6 | 1.6 | 0.5 | 0.4 | 1.8 | 1.7 | 2.4 | 2.5 | 2.7 | 3.2 | – | 4.2 | 1.7 | 2.8 | 3.5 | 3.2 | 4.1 | 4.4 | 17.3 | 1.7 | 19.1 |
| Intensity Change (Log2) | – | – | – | -0.05 | 0.23 | 0.38 | 0.47 | 0.48 | 0.35 | 0.34 | – | 0.61 | 0.44 | 0.7 | 0.85 | 1.13 | 1.43 | 1.36 | 1.11 | 0.39 | 1.21 |
Localization Change
| Localization | RAP60 | RAP140 | RAP220 | RAP300 | RAP380 | RAP460 | RAP540 | RAP620 | RAP700 | HU80 | HU120 | HU160 | rpd3Δ_1 | rpd3Δ_2 | rpd3Δ_3 |
|---|---|---|---|---|---|---|---|---|---|---|---|---|---|---|---|
| Actin | – | – | – | – | – | – | – | – | – | – | – | – | – | – | – |
| Bud | – | 0 | 0 | 0 | 0 | 0 | 0 | – | 0 | 0 | 0 | 0 | 0 | 0 | 0 |
| Bud Neck | – | 0 | 0 | 0 | 0 | 0 | 0 | – | 0 | 0 | 0 | 0 | 0 | 0 | 0 |
| Bud Site | – | 0 | 0 | 0 | 0 | 0 | 0 | – | 0 | 0 | 0 | 0 | 0 | 0 | 0 |
| Cell Periphery | – | 0 | 0 | 0 | 0 | 0 | 0 | – | 0 | 0 | 0 | 0 | 0 | 0 | 0 |
| Cyto | – | – | – | – | – | – | – | – | – | – | – | – | – | – | – |
| Endoplasmic Reticulum | – | 0 | 0 | 0 | 0 | 0 | 0 | – | 0 | 0 | 0 | 0 | 0 | 0 | 0 |
| Endosome | – | 0 | 0 | 0 | 0 | 0 | 0 | – | 0 | 0 | 0 | 0 | 0 | 0 | 0 |
| Golgi | – | 0 | 0 | 0 | 0 | 0 | 0 | – | 0 | 0 | 0 | 0 | 0 | 0 | 0 |
| Mitochondria | – | 0 | 0 | 0 | 0 | 0 | 0 | – | 0 | 0 | 0 | 0 | 0 | 0 | 0 |
| Nuclear Periphery | – | 0 | 0 | 0 | 0 | 0 | 0 | – | 0 | 0 | 0 | 0 | 0 | 0 | 0 |
| Nuc | – | – | – | – | – | – | – | – | – | – | – | – | – | – | – |
| Nucleolus | – | 0 | 0 | 0 | 0 | 0 | 0 | – | 0 | 0 | 0 | 0 | 0 | 0 | 0 |
| Peroxisomes | – | 0 | 0 | 0 | 0 | 0 | 0 | – | 0 | 0 | 0 | 0 | 0 | 0 | 0 |
| SpindlePole | – | 0 | 0 | 0 | 0 | 0 | 0 | – | 0 | 0 | 0 | 0 | 0 | 0 | 0 |
| Vac | – | – | – | – | – | – | – | – | – | – | – | – | – | – | – |
| Cortical Patches | – | 0 | 0 | 0 | 0 | 0 | 0 | – | 0 | 0 | 0 | 0 | 0 | 0 | 0 |
| Cytoplasm | – | -1.3 | -1.9 | -2.0 | -2.9 | -2.8 | -3.0 | – | -2.4 | -0.7 | -0.5 | -0.4 | -0.7 | -1.0 | -1.0 |
| Nucleus | – | 0 | 0 | 0 | 0 | 0 | 0 | – | 0 | 0 | 0 | 0 | 0 | 0 | 0 |
| Vacuole | – | 0 | 0 | 0 | 0 | 0 | 0 | – | 0 | 0 | 0 | 0 | 0 | 0 | 0 |
External localization resources
Images






























Protein Concentration and Protein Localization Data
| R1 | R2 | R3 | ||||||||||||||||
|---|---|---|---|---|---|---|---|---|---|---|---|---|---|---|---|---|---|---|
| G1 Pre-START | G1 Post-START | S/G2 | Metaphase | Anaphase | Telophase | G1 Pre-START | G1 Post-START | S/G2 | Metaphase | Anaphase | Telophase | G1 Pre-START | G1 Post-START | S/G2 | Metaphase | Anaphase | Telophase | |
| Concentration | 4.275 | 3.1738 | 2.8474 | 3.3465 | 2.8533 | 3.2627 | 12.053 | 12.5208 | 12.6372 | 11.5783 | 11.6937 | 12.9677 | 7.0506 | 7.6174 | 6.836 | 6.8307 | 6.6893 | 7.3705 |
| Actin | 0.0292 | 0.0059 | 0.0064 | 0.0005 | 0.0003 | 0.0004 | 0.0144 | 0.0009 | 0.0039 | 0.001 | 0.0064 | 0.0076 | 0.0298 | 0.0084 | 0.0138 | 0.0106 | 0.0218 | 0.0039 |
| Bud | 0.0002 | 0.0011 | 0.0003 | 0.0002 | 0.0001 | 0.0002 | 0.0058 | 0.0007 | 0.0009 | 0.0002 | 0.0032 | 0.0014 | 0.0007 | 0.0049 | 0.0015 | 0.0016 | 0.0002 | 0.0006 |
| Bud Neck | 0.0011 | 0.0003 | 0.0008 | 0.0004 | 0.0004 | 0.0011 | 0.0052 | 0.0003 | 0.0005 | 0.0007 | 0.0007 | 0.0015 | 0.0007 | 0.0004 | 0.0013 | 0.0035 | 0.0006 | 0.0055 |
| Bud Periphery | 0.0002 | 0.0002 | 0.0002 | 0.0001 | 0 | 0.0001 | 0.0062 | 0.0001 | 0.0004 | 0.0001 | 0.0017 | 0.0011 | 0.0007 | 0.0015 | 0.0011 | 0.0011 | 0.0003 | 0.0003 |
| Bud Site | 0.0006 | 0.0019 | 0.0009 | 0.0001 | 0.0001 | 0.0001 | 0.004 | 0.0033 | 0.0007 | 0.0002 | 0.0003 | 0.0002 | 0.0011 | 0.0107 | 0.0039 | 0.0013 | 0.0004 | 0.0016 |
| Cell Periphery | 0.0001 | 0.0001 | 0.0001 | 0 | 0 | 0 | 0.0003 | 0.0001 | 0.0001 | 0 | 0 | 0 | 0.0001 | 0.0002 | 0.0003 | 0.0001 | 0.0002 | 0.0001 |
| Cytoplasm | 0.8233 | 0.8684 | 0.8669 | 0.9254 | 0.9359 | 0.9125 | 0.8374 | 0.9523 | 0.9182 | 0.926 | 0.9335 | 0.9132 | 0.746 | 0.866 | 0.8655 | 0.7935 | 0.7244 | 0.8602 |
| Cytoplasmic Foci | 0.0076 | 0.0042 | 0.0076 | 0.0072 | 0.0092 | 0.0087 | 0.0127 | 0.0024 | 0.006 | 0.0044 | 0.0068 | 0.0064 | 0.0273 | 0.0056 | 0.0035 | 0.0186 | 0.0056 | 0.0117 |
| Eisosomes | 0.0002 | 0.0001 | 0.0001 | 0 | 0 | 0 | 0.0001 | 0 | 0 | 0 | 0 | 0 | 0.0001 | 0 | 0.0001 | 0 | 0.0003 | 0.0001 |
| Endoplasmic Reticulum | 0.0047 | 0.0028 | 0.0058 | 0.0017 | 0.0014 | 0.0027 | 0.0046 | 0.0014 | 0.0017 | 0.0018 | 0.0044 | 0.0023 | 0.0045 | 0.002 | 0.004 | 0.0059 | 0.0086 | 0.0027 |
| Endosome | 0.0087 | 0.0015 | 0.0073 | 0.0011 | 0.0016 | 0.0042 | 0.0129 | 0.0007 | 0.0011 | 0.001 | 0.0066 | 0.0034 | 0.0155 | 0.0055 | 0.0043 | 0.021 | 0.0149 | 0.0035 |
| Golgi | 0.0021 | 0.0002 | 0.0007 | 0.0001 | 0.0001 | 0.0001 | 0.003 | 0.0001 | 0.0005 | 0.0001 | 0.0006 | 0.0009 | 0.0046 | 0.0018 | 0.002 | 0.0031 | 0.0044 | 0.0012 |
| Lipid Particles | 0.0014 | 0.0001 | 0.0004 | 0.0002 | 0 | 0.0001 | 0.0023 | 0 | 0.0002 | 0.0001 | 0.0001 | 0.0018 | 0.0059 | 0.0006 | 0.001 | 0.0008 | 0.0096 | 0.0016 |
| Mitochondria | 0.0006 | 0.0002 | 0.0003 | 0.0001 | 0.0001 | 0.0002 | 0.0025 | 0.0001 | 0.0003 | 0.0002 | 0.0007 | 0.0003 | 0.0021 | 0.0012 | 0.0057 | 0.0014 | 0.0065 | 0.0006 |
| None | 0.0893 | 0.1017 | 0.087 | 0.0545 | 0.0426 | 0.0498 | 0.0256 | 0.0189 | 0.0434 | 0.0317 | 0.0048 | 0.019 | 0.1111 | 0.0763 | 0.0757 | 0.08 | 0.0668 | 0.0914 |
| Nuclear Periphery | 0.007 | 0.0011 | 0.0031 | 0.0012 | 0.0013 | 0.002 | 0.0099 | 0.0015 | 0.0017 | 0.0014 | 0.0044 | 0.0029 | 0.0131 | 0.0027 | 0.0029 | 0.0151 | 0.0432 | 0.0027 |
| Nucleolus | 0.0002 | 0.0001 | 0.0001 | 0 | 0 | 0.0001 | 0.0003 | 0 | 0.0001 | 0 | 0 | 0.0001 | 0.0004 | 0.0001 | 0.0006 | 0.0004 | 0.0005 | 0.0001 |
| Nucleus | 0.0186 | 0.0075 | 0.0082 | 0.0059 | 0.0045 | 0.0141 | 0.0413 | 0.0155 | 0.0161 | 0.0289 | 0.0222 | 0.0336 | 0.0175 | 0.0082 | 0.0087 | 0.0129 | 0.0134 | 0.0077 |
| Peroxisomes | 0.0006 | 0.0004 | 0.0003 | 0.0001 | 0.0003 | 0.0001 | 0.0024 | 0.0001 | 0.0018 | 0.0002 | 0.0005 | 0.0009 | 0.0096 | 0.0008 | 0.0005 | 0.0034 | 0.072 | 0.0005 |
| Punctate Nuclear | 0.0027 | 0.0009 | 0.0012 | 0.0007 | 0.0015 | 0.0021 | 0.0061 | 0.0009 | 0.0017 | 0.0015 | 0.0018 | 0.0024 | 0.0074 | 0.0015 | 0.0016 | 0.0231 | 0.0024 | 0.0035 |
| Vacuole | 0.0011 | 0.0011 | 0.0019 | 0.0005 | 0.0005 | 0.0011 | 0.0022 | 0.0005 | 0.0006 | 0.0003 | 0.001 | 0.0007 | 0.001 | 0.0014 | 0.0015 | 0.0018 | 0.0014 | 0.0006 |
| Vacuole Periphery | 0.0004 | 0.0001 | 0.0003 | 0.0001 | 0.0001 | 0.0002 | 0.0008 | 0.0001 | 0.0001 | 0.0001 | 0.0002 | 0.0002 | 0.0008 | 0.0003 | 0.0003 | 0.0006 | 0.0024 | 0.0002 |
Sequencing Data
| R1 | R2 | |||||||||
|---|---|---|---|---|---|---|---|---|---|---|
| G1 Post-START | S/G2 | Metaphase | Anaphase | Telophase | G1 Post-START | S/G2 | Metaphase | Anaphase | Telophase | |
| Gene Expression | – | – | – | – | – | – | – | – | – | – |
| Translational Efficiency | – | – | – | – | – | – | – | – | – | – |
Hit Data
| Dataset | Hit |
|---|---|
| Protein Concentration | ✘ |
| Protein Localization | ✘ |
| Gene Expression | – |
| Translational Efficiency | – |
Endocytosis
| Temp | Actin Patch (Sac6-tdTomato) | Cortical Patch (Sla1-GFP) | Late Endosome (Snf7-GFP) | Vacuole (Vph1-GFP) |
|---|---|---|---|---|
| 37℃ | ||||
| RT |
Cell Cycle Omics
CYCLoPs (Sol4-GFP)
| Gene / Allele | Actin Patch (Sac6-tdTomato) | Cortical Patch (Sla1-GFP) | Late Endosome (Snf7-GFP) | Vacuole (Sac6-tdTomato) |
|---|
| Gene | Images |
|---|
| Gene | Images |
|---|
Images are not yet available
Images are not yet available